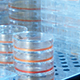
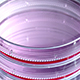

クローズアップRIKEN 2023
研究現場で活躍するフロントランナーを取材する「研究最前線」、理研の新しい取り組みや異分野の専門家たちとの対談を紹介する「特集」、また研究者がひとりの人間として科学への思いや向き合い方を語る「私の科学道」など、読み応えのあるインタビュー記事を随時更新しています。
- ※本コンテンツは、2025年度より「クローズアップ科学道」から「クローズアップRIKEN」にタイトルを変更いたしました。
12月

研究最前線 2023年12月25日
巨大実験データを活用するための「SPring-8データセンター構想」
研究最前線 2023年12月19日
有袋類、爬虫類…モデル動物新時代
研究最前線 2023年12月12日
100年前の数式を見直し、酵素の働きを最大に
研究最前線 2023年12月7日
アーキアの分子モーターが動く仕組みを探究
研究最前線 2023年12月4日
進化する、疾患モデルマウスの最前線
11月

研究最前線 2023年11月30日
ロボットは「道徳的行為者」になれるのか!?
研究最前線 2023年11月27日
不安定な原子核の内部構造の観測に成功
研究最前線 2023年11月21日
ヒトの脳の理解に近づく「脳の地図づくり」
私の科学道 2023年11月15日
分子生物学者は越境して進む
研究最前線 2023年11月9日
早期胃がんを見つけるAI
10月

研究最前線 2023年10月30日
光量子コンピュータのための重要なピース完成
9月

研究最前線 2023年9月21日
転写の瞬間を撮影して、生物学上の長年の謎を解決!
特集 2023年9月12日
神戸市の防災計画にデジタルツインを生かす
特集 2023年9月4日
量子コンピュータ開発に挑む若手研究者たち
8月

私の科学道 2023年8月28日
「システム生物学」で分子生命科学に革新を
研究最前線 2023年8月21日
ゲノムの未開拓領域を切り開く!
研究最前線 2023年8月10日
「心の病を治したい」根治療法を求めて
研究最前線 2023年8月4日
がんの治療に新元素合成で貢献
7月

研究最前線 2023年7月31日
励起した分子1個の光電流を計測
研究最前線 2023年7月3日
共生微生物で環境問題を解決
6月

研究最前線 2023年6月26日
超高速で変化するタンパク質の動きを捉える
研究最前線 2023年6月19日
サイエンスのプラットフォームとしての「富岳」
私の科学道 2023年6月12日
気付いたら量子ビットができていた
研究最前線 2023年6月7日
数理モデルで複雑な生態系の謎に迫る
研究最前線 2023年6月2日
早く、正確に!手法の改良につながった解析の日々
5月
研究最前線 2023年5月24日
神経疾患の鍵を握る細胞の“品質管理”
研究最前線 2023年5月15日
腸内細菌と肥満・糖尿病を結ぶメカニズム
4月

研究最前線 2023年4月20日
胃がんリスクにおけるピロリ菌感染と遺伝要因
研究最前線 2023年4月14日
「生えないはずのカビ」に刻まれた進化の歴史
研究最前線 2023年4月4日
耕作適地の拡大に貢献!タンパク質の立体構造解析
3月

特集 2023年3月30日
基礎科学特別研究員インタビュー⑤ 生体内現象をDNAに記録する技術を開発したい
特集 2023年3月27日
基礎科学特別研究員インタビュー④ 自分の研究に没頭できる、人生の中で貴重な時間
特集 2023年3月20日
基礎科学特別研究員インタビュー③ 研究に専念できるパラダイス
特集 2023年3月15日
基礎科学特別研究員インタビュー② 38歳でたどり着いた数学者としての大きな第一歩
研究最前線 2023年3月9日
マウスクローン技術の実用化に向けた挑戦
特集 2023年3月2日
基礎科学特別研究員インタビュー① 研究者としての道をつないでくれた
2月

私の科学道 2023年2月22日
「知りたい」「見たい」がすべての原動力
研究最前線 2023年2月16日
化学反応に魅せられて
研究最前線 2023年2月7日
植物再生の不思議に挑み続けて
1月

研究最前線 2023年1月31日
常温で水の核スピンの向きをそろえる
研究最前線 2023年1月25日
水素社会の鍵を握る「水素吸着材料」
研究最前線 2023年1月18日
人工冬眠が臓器のダメージを防ぐ可能性
研究最前線 2023年1月11日
細胞製剤でがんの免疫療法を実現へ
